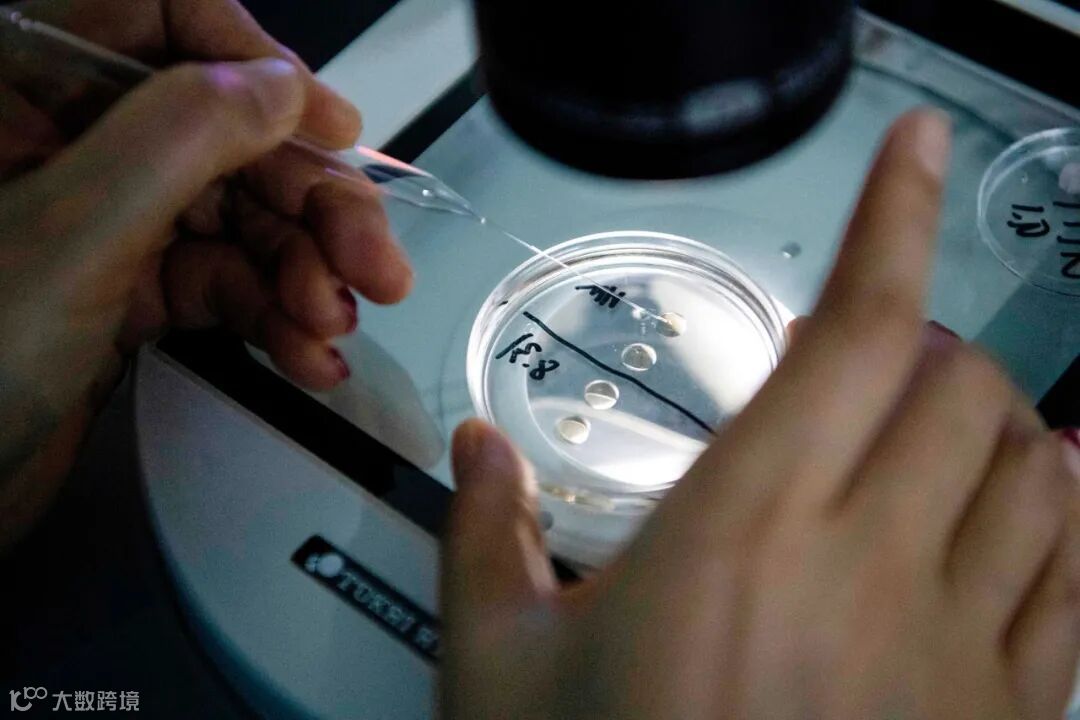

“女子花25万元成功克隆去世宠物狗”
“上海奶奶花18万克隆宠物”
……
你会克隆自己去世的爱宠吗?

当爱宠离世,有人选择庄重告别,有人却选择他日再会。前者诞育了宠物殡葬这一职业;后者,开始让宠物复活成为生意。
难以接受宠物离世的事实,希望让这份陪伴延续下去,这些都是人之常情。现实生活中,“毛孩子”们早已成为很多家庭不可分割的一部分,当宠物骤然离去,过去经历的点点滴滴涌上心头,很多人都会感觉“心被掏空”,陷入巨大的痛苦和失落情绪之中。有媒体曾就“你会克隆去世的宠物吗?”进行网络调查,参与投票的10万人中,有2.6万余人选择“会”,或“经济条件允许就会”。
作为宠物经济高端消费的新兴赛道,死而复生和天价花费,无疑都是极具吸睛性的噱头,那么,看起来颇具神秘色彩的宠物克隆行业,其“庐山真面目”究竟是怎样的?
01
1996年,世界上第一只体细胞克隆动物绵羊多莉诞生,拉开了利用生物技术“无性繁殖”的帷幕。彼时,该研究虽被美国《科学》杂志评为1997年世界十大科技进步的第一项,但也曾遭遇极为激烈的伦理争议。

时间过去近30年,如今学界对动物克隆技术普遍抱持着更为欢迎的姿态。我国食品药品检定研究院实验动物资源研究所所长、国家实验动物专家委员会副主任委员贺争鸣曾公开“点赞”,称克隆技术对保护生物多样性贡献甚伟,为挽救濒危野生动物提供了一个全新的切入点。
克隆技术自滥觞之日便一路高歌,由实验室走入商用领域,逐渐从濒危动物保护、畜牧、生物医药等B端市场,延伸向了更为贴近人们日常生活的C端——“它经济”。
那么,“复制”宠物究竟是如何实现的?

世界首个体细胞克隆猴“中中”(左)和它的妹妹“华华”(右)
从原生宠物的身体上取得一小块皮肤组织,由此培养出供体细胞的“建系”过程,被公认是操作关键。一旦建系成功,只需将一枚含有遗传物质的供体细胞核,移植到去除了细胞核的受体卵细胞中,利用微电流刺激两者合二为一,促使这一新细胞分裂、繁殖、发育成胚胎,再植入代孕动物子宫中继续发育,便可产下与原生宠物基因相同的克隆动物。
通常来说,自活体动物取样的建系成功率一般在80%-95%;若待动物去世后才提取组织,建系成功的可能性就要下滑至60%-80%。即使同是死去的动物,死亡时年龄小的,也要比年龄大的易于建系。总之,越年轻、越健康的动物细胞活性越高,建系成功率自然越高。

克隆猫CC在实验室长大
目前在国内,上门取样费一般在2500元左右,细胞保存则需每年再支付2000-5000元不等。加上17万元到22万元的克隆费,成功再造一条小型犬的花销,通常不低于20万元。若需多次取样、长时间保存细胞,总体费用还要攀高。
鉴于克隆宠物属于整体复制,理论上并没有产生可能带来危害的新型物种,因此国内外都没有禁止此业的成文法规。在利润空间的驱动和成本优势的加持下,中国生物技术企业如希诺谷,与韩国秀岩生命工学研究院的黄禹锡团队、美国ViaGen Pet,共同形成了瓜分宠物克隆商业化“蓝海”的三足鼎立之势。
02
首先,克隆并不意味着一比一“复制”,从基因水平上说,克隆宠物更像是不同时间出生的同卵双胞胎。所以,严格来说,克隆宠物完全是一个新的生命个体,无法承载原先的感情和记忆。用“复活”宠物的标准去要求它,恐怕不仅会让自己失望,对新生命而言也并不公平。
其次,也许在商业机构的宣传中,更多将重点放在“重获宠物”的美好概念打造中,但在以爱之名的“重生”背后,宠物克隆的实际操作却十分残忍。克隆公司会给供卵母猫注射激素,诱导其发情并刺激排卵。然后剖开母猫腹部,向暴露出的输卵管注射冲卵液,以刺激卵子流出。待到建系完毕、胚胎发育后,另有母猫被开腹植入胚胎进行代孕。
根据国内一家克隆公司的官网信息,克隆一只猫,平均需要10个胚胎和3只代孕母体,来保证胚胎质量,以及防范胎停、被母体“吸收”或流产等意外情况。也就是说,想要重得自己的昔日爱宠,大约需要13只其他的猫开肠破肚,痛苦地贡献出自己的卵巢和子宫。据透露用来取卵代孕的“工具猫”,一生都被关在暗无天日的笼中,为了提高母体的利用率以节约成本,一只猫一年至少要被开腹2次。
而在探索宠物克隆技术的初期,沦为牺牲品的无辜动物更是难以胜数。2005年,韩国科学家培育了超1000个胚胎,植入123只代孕母亲体内,最后才培育出一只克隆犬“史努比”。

克隆犬“史努比”
第三,每一个“完美”的“复刻宠物”背后,都可能有着无数个无辜的生命被牺牲、被抛弃。有科普博主指出,为保证成功率,机构一般都会克隆出多只“替代品”,并选择长相最接近的那只“幸运替代品”交付到主人手里。
而那些没被选中的小动物则面临着灰暗的命运——母猫沦为克隆生产线上的下一波“消耗品”成为供卵和代孕工具,公猫则会被直接处理掉。至此,一次宠物克隆才彻底宣告完成。

研究者正在提取卵子
03
据商家宣传,克隆体与宠物本体的DNA同一性高达99%,而基因序列相同,不仅指向了高度相似的身体结构和外貌特征,就连一些先天能力和生活习性都可以实现复刻。
但如此理想化的名头之下,其实可副吗?
商家表示,会提供第三方出具的鉴定书来保证品质。并且,长期跟踪服务中发现,客户普遍都给出了外貌、习惯等方面相似度很高的正面反馈。
譬如,2018年由公安部昆明警犬基地牵头,云南农业大学和希诺谷展开合作,利用优秀功勋犬体细胞培育出的首只克隆警犬“昆勋”,在后期警用素质测试中表现出来的潜质,就远高于同类昆明犬。
但另一方面,克隆公司也承认,无法承诺克隆体对本体主观性特征的绝对还原,不仅性格、脾气、爱好有可能不一样,样貌差异也难以避免。如世界上第一只克隆猫CC,与其本体Rainbow的花色纹路就并不相似,长相谈不上“以假乱真”,相反,可说是截然不同。
更何况,克隆技术在99%的DNA序列同一性之外,还天然存在着1%的差异。此外,还有大量案例证明,生物的个性和行为不仅受原始基因左右,生长环境、成长经历都会影响特征的表达。

业内人士形象地把克隆技术比喻为遗传基因的“搬运工”从本质上来讲,克隆只是遗传物质的人工组合,并没有创造新的遗传物质。”2017年,我国科学家运用基因编辑和克隆技术,成功培育出第一只国产克隆犬“龙龙”。两年之后,我国第一只国产克隆猫“大蒜”诞生,让它们的主人——北京希诺谷生物科技有限公司浮出水面,也间接宣告中国突破技术难题,进入了克隆宠物的商业化赛道。
资料显示,北京希诺谷生物科技有限公司专注于动物基因科技,是拥有完全自主知识产权的商业化克隆宠物企业,拥有国际领先的基因编辑犬技术,目前已经历经了四轮融资。短短几年间,北京希诺谷生物科技有限公司迅速崛起,成了国内克隆宠物行业的头部企业。截至目前,该公司交付了近500只克隆宠物,经长期跟踪随访,这些克隆宠物的生长和健康状况都非常好。

虽然克隆宠物已经进入商业化快车道,但在国外,抗议之声时有耳闻。尽管随着克隆技术的不断成熟,动物福利已经大大提升,但一些动物保护人士仍然抵制克隆宠物,认为商业机构每克隆一只宠物,就会牺牲无数只实验动物,这完全是为了满足个人的一己私利而残害无数动物,“很残忍”。
更多的质疑声,聚焦在克隆宠物的价值和意义。反对者认为,克隆宠物并不能真正让爱宠死而复生,它只不过是一剂情感安慰剂,甚至有收割智商税的嫌疑。
而一旦克隆体与原宠物出现差异,宠物主感到难以重建情感联系,就有可能在失望之下冷待甚至弃养新宠物。这不仅造成了消费者财产和情感的双重损失,也给无辜的新生命造成了极大伤害。
可见,在商业机构描绘的“重获宠物”的动人图景之下,其实掩映着太多关乎技术和伦理的问题。因此,在法律监管仍有待完善、克隆技术对动物伤害仍然较大的情况下,选择克隆宠物的确需要三思而后行。
◆ 来源:宠商汇
◆ 本号声明:如有侵权,请联系我们进行删除





 北京市京师(
北京市京师(